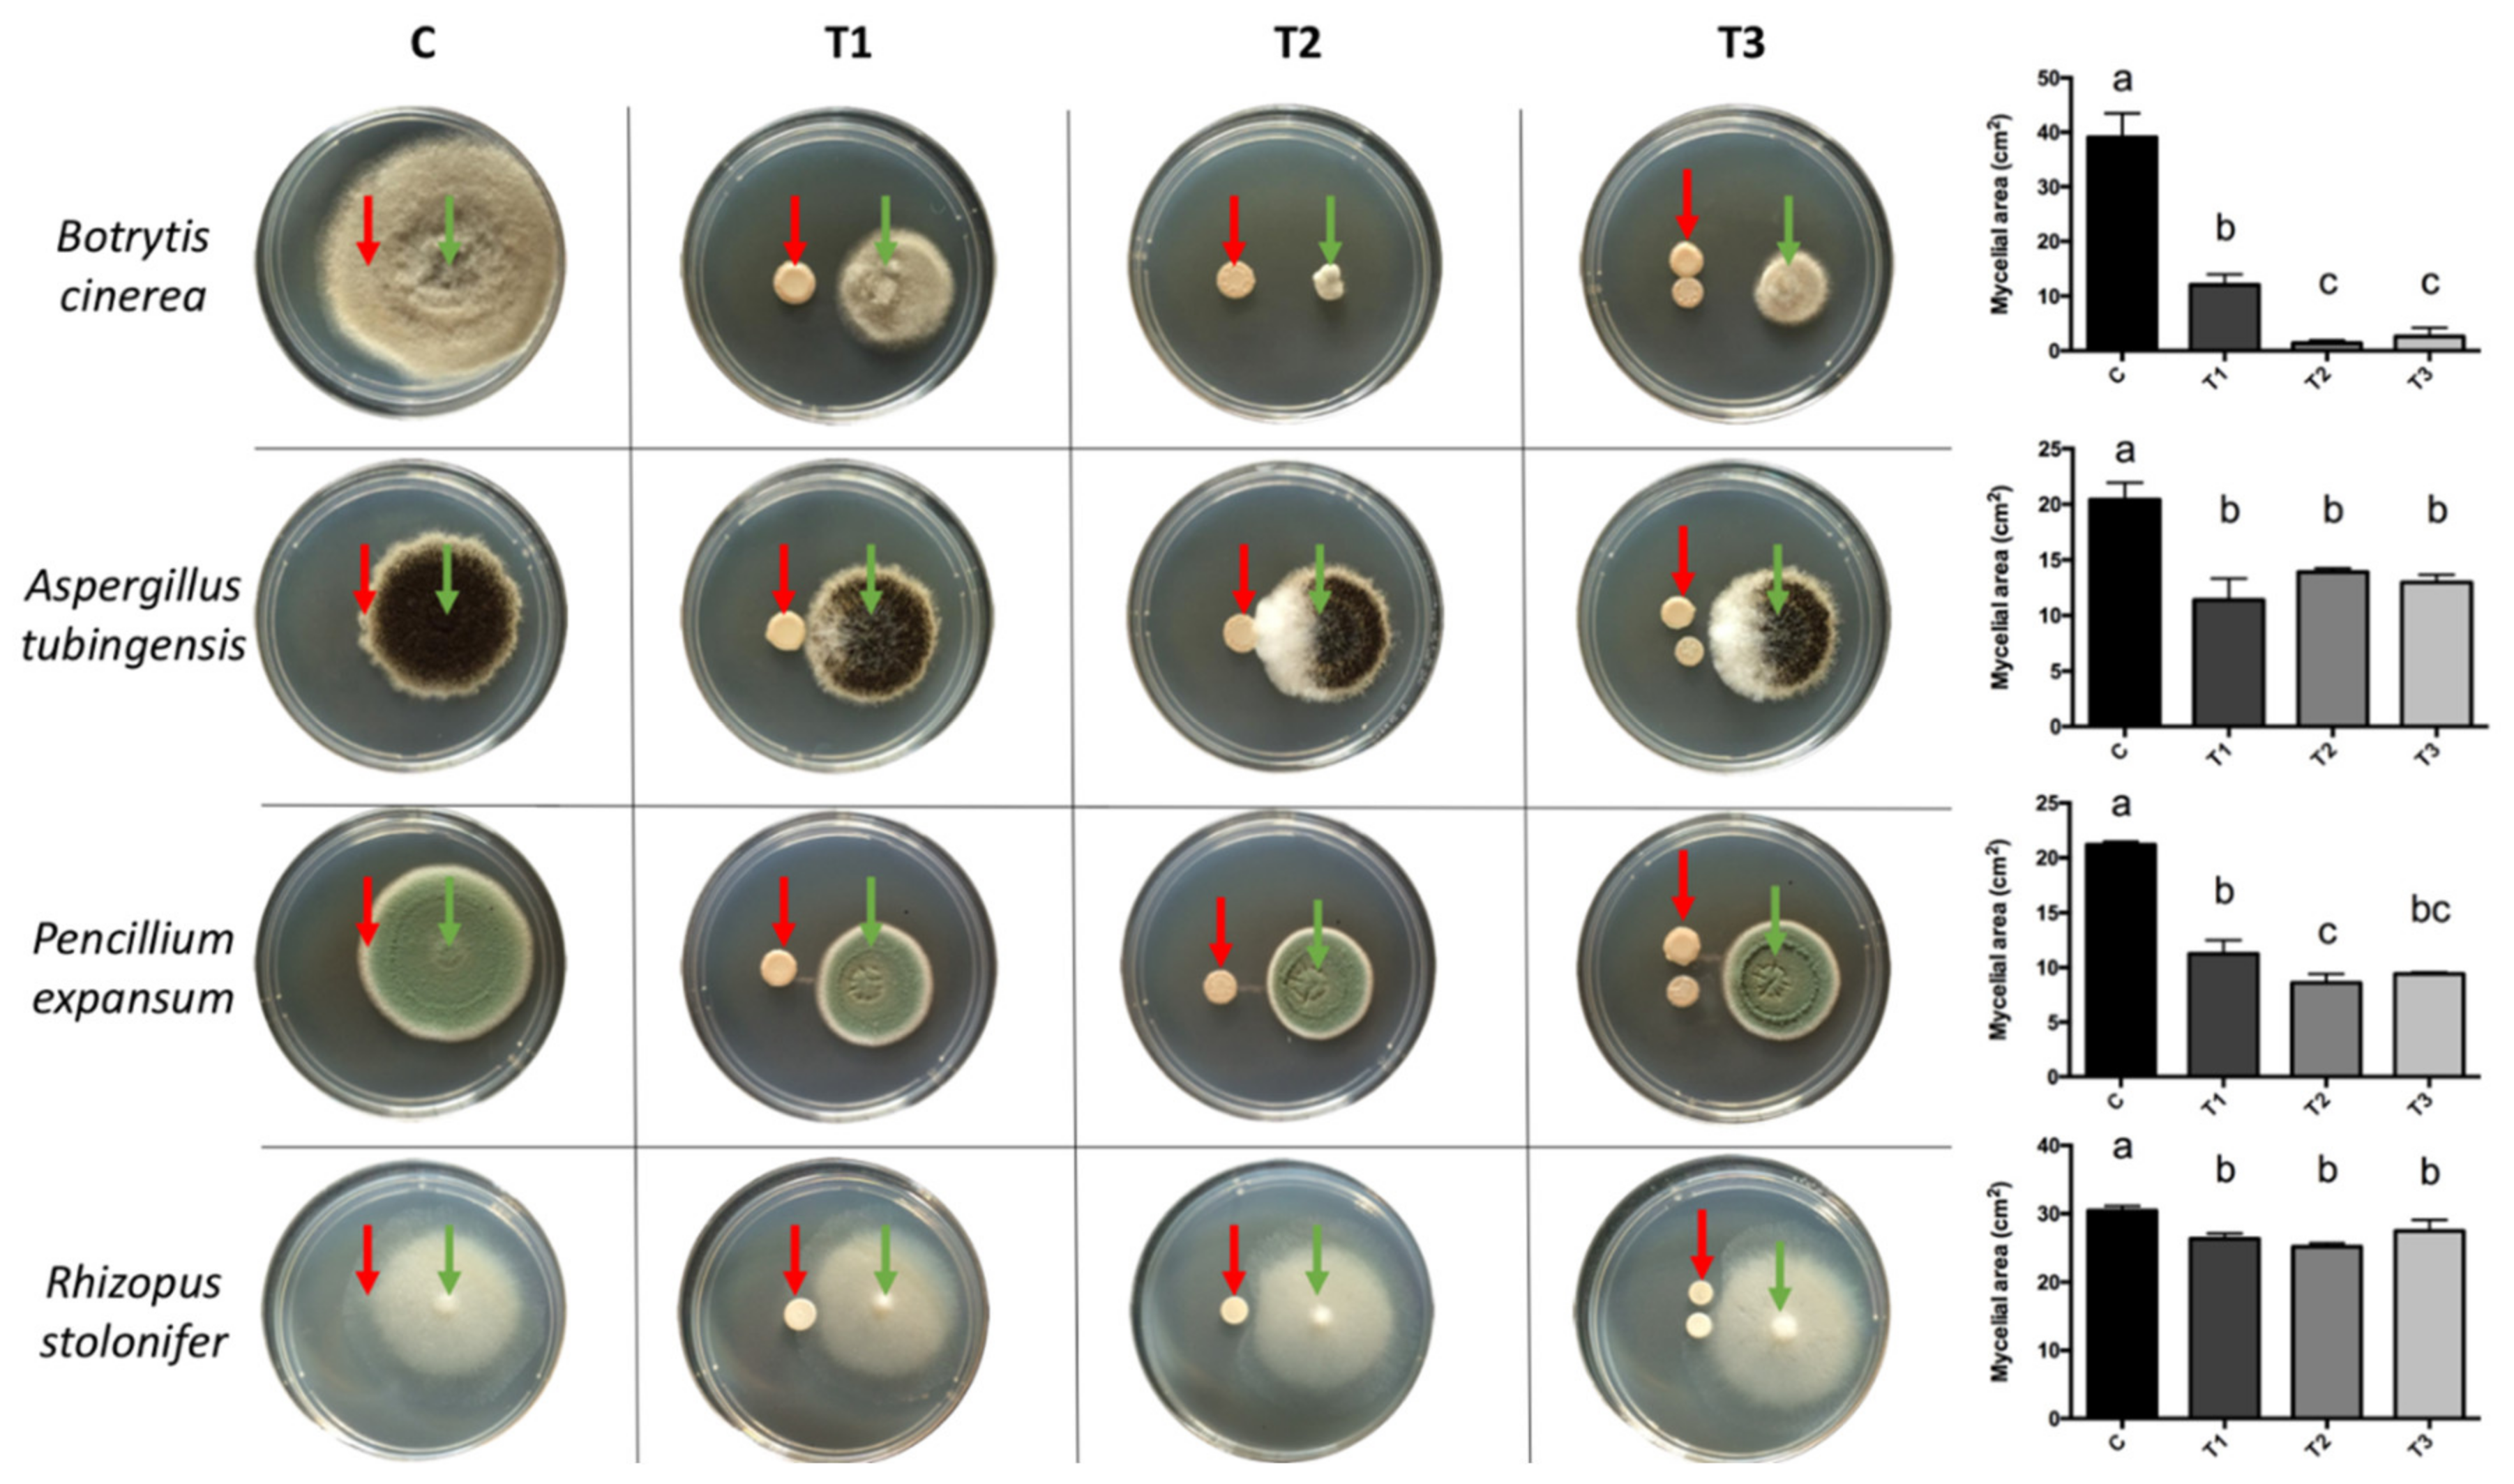
Antibiotics 10 00664 g001 Antibiotics 10 00664 g001

Diffusible Compounds Produced by Hanseniaspora osmophila and Gluconobacter cerinus Help to Control the Causal Agents of Gray Rot and Summer Bunch Rot of Table Grapes
Abstract
1. Introduction
2. Results and Discussion
2.1. Morphological and Molecular Identification of Pathogens
2.2. In Vitro Effect of Diffusible Compounds Produced by BCAs
2.3. Extraction of Diffusible Compounds and Extract Evaluation
2.4. Separation and Evaluation of the Extract
2.5. Identification of the Active Compounds of the Extract
3. Materials and Methods
3.1. Morphological and Molecular Identification of Pathogens
3.2. In Vitro Effect of Diffusible Organic Compounds Produced by the BCAs on the Pathogenic Fungi
3.3. Extraction of Diffusible Compounds and Evaluation of Extracts
3.4. Separation and Evaluation of the Extract
3.5. Identification of Extract Active Compounds
3.6. Statistical Analysis
4. Conclusions
5. Patents
Author Contributions
Funding
Acknowledgments
Conflicts of Interest
References
- CIREN-ODEPA. Catastro Frutícola Región del Maule; Larrañaga, P., Osores, M.A., Eds.; ODEPA: Santiago, Chile, 2019; p. 48. [Google Scholar]
- Duncan, R.A.; Stapleton, J.J.; Leavitt, G.M. Population dynamics of epiphytic mycoflora and occurrence of bunch rots of wine grapes as influenced by leaf removal. Plant Pathol. 1995, 44, 956–965. [Google Scholar] [CrossRef]
- Williamson, B.; Tudzynski, B.; Tudzynski, P.; Van Kan, J.A.L. Botrytis cinerea: The cause of grey mould disease. Mol. Plant Pathol. 2007, 8, 561–580. [Google Scholar] [CrossRef]
- Fillinger, S.; Walker, A.S. Chapter 10: Chemical control and resistance management of Botrytis diseases. In Botrytis—The Fungus, the Pathogen and Its Management in Agricultural Systems; Fillinger, S., Elad, Y., Eds.; Springer: New York, NY, USA, 2015; pp. 1–486. ISBN 9783319233710. [Google Scholar]
- Esterio, M.; Auger, J.; Ramos, C.; Walker, A.; Muñoz, G.; Fillinger, S. Botrytis en uva de mesa de exportación: Situación actual de sensibilidad a fungicidas en Chile. Aconex 2009, 103, 16–23. [Google Scholar]
- Dean, R.; Van Kan, J.A.L.; Pretorius, Z.A.; Hammond-Kosack, K.E.; Di Pietro, A.; Spanu, P.D.; Rudd, J.J.; Dickman, M.; Kahmann, R.; Ellis, J.; et al. The Top 10 fungal pathogens in molecular plant pathology. Mol. Plant Pathol. 2012, 13, 414–430. [Google Scholar] [CrossRef]
- Latorre, B.A.; Spadaro, I.; Rioja, M.E. Occurrence of resistant strains of Botrytis cinerea to anilinopyrimidine fungicides in table grapes in Chile. Crop Prot. 2002, 21, 957–961. [Google Scholar] [CrossRef]
- Latorre, B.A.; Torres, R. Prevalence of isolates of Botrytis cinerea resistant to multiple fungicides in Chilean vineyards. Crop Prot. 2012, 40, 49–52. [Google Scholar] [CrossRef]
- Aoki, T.; Aoki, Y.; Ishiai, S.; Otoguro, M.; Suzuki, S. Impact of Bacillus cereus NRKT on grape ripe rot disease through resveratrol synthesis in berry skin. Pest Manag. Sci. 2017, 73, 174–180. [Google Scholar] [CrossRef] [PubMed]
- Carbó, A.; Torres, R.; Usall, J.; Marín, A.; Chiralt, A.; Teixidó, N. Novel film-forming formulations of the biocontrol agent Candida sake CPA-1: Biocontrol efficacy and performance at field conditions in organic wine grapes. Pest Manag. Sci. 2019, 75, 959–968. [Google Scholar] [CrossRef] [PubMed]
- Calvo-Garrido, C.; Viñas, I.; Elmer, P.A.; Usall, J.; Teixidó, N. Suppression of Botrytis cinerea on necrotic grapevine tissues by early-season applications of natural products and biological control agents. Pest Manag. Sci. 2014, 70, 595–602. [Google Scholar] [CrossRef] [PubMed]
- Rotolo, C.; De Miccolis Angelini, R.M.; Dongiovanni, C.; Pollastro, S.; Fumarola, G.; Di Carolo, M.; Perrelli, D.; Natale, P.; Faretra, F. Use of biocontrol agents and botanicals in integrated management of Botrytis cinerea in table grape vineyards. Pest Manag. Sci. 2018, 74, 715–725. [Google Scholar] [CrossRef]
- Barata, A.; Malfeito-Ferreira, M.; Loureiro, V. The microbial ecology of wine grape berries. Int. J. Food Microbiol. 2012, 153, 243–259. [Google Scholar] [CrossRef]
- Barata, A.; Santos, S.C.; Malfeito-Ferreira, M.; Loureiro, V. New Insights into the Ecological Interaction Between Grape Berry Microorganisms and Drosophila Flies During the Development of Sour Rot. Microb. Ecol. 2012, 64, 416–430. [Google Scholar] [CrossRef] [PubMed]
- Barata, A.; Malfeito-Ferreira, M.; Loureiro, V. Changes in sour rotten grape berry microbiota during ripening and wine fermentation. Int. J. Food Microbiol. 2012, 154, 152–161. [Google Scholar] [CrossRef]
- Mateo, E.; Torija, M.J.; Mas, A.; Bartowsky, E.J. Acetic acid bacteria isolated from grapes of South Australian vineyards. Int. J. Food Microbiol. 2014, 178, 98–106. [Google Scholar] [CrossRef]
- Valera, M.J.; Laich, F.; González, S.S.; Torija, M.J.; Mateo, E.; Mas, A. Diversity of acetic acid bacteria present in healthy grapes from the Canary Islands. Int. J. Food Microbiol. 2011, 151, 105–112. [Google Scholar] [CrossRef]
- Guzzon, R.; Franciosi, E.; Larcher, R. A new resource from traditional wines: Characterization of the microbiota of “vino santo” grapes as a biocontrol agent against botrytis cinerea. Eur. Food Res. Technol. 2014, 239, 117–126. [Google Scholar] [CrossRef]
- Cai, Z.; Yang, R.; Xiao, H.; Qin, X.; Si, L. Effect of preharvest application of Hanseniaspora uvarum on postharvest diseases in strawberries. Postharvest Biol. Technol. 2015, 100, 52–58. [Google Scholar] [CrossRef]
- Qin, X.; Xiao, H.; Xue, C.; Yu, Z.; Yang, R.; Cai, Z.; Si, L. Biocontrol of gray mold in grapes with the yeast Hanseniaspora uvarum alone and in combination with salicylic acid or sodium bicarbonate. Postharvest Biol. Technol. 2015, 100, 160–167. [Google Scholar] [CrossRef]
- Li, W.; Zhang, H.; Li, P.; Apaliya, M.T.; Yang, Q.; Peng, Y.; Zhang, X. Biocontrol of postharvest green mold of oranges by Hanseniaspora uvarum Y3 in combination with phosphatidylcholine. Biol. Control 2016, 103, 30–38. [Google Scholar] [CrossRef]
- Prendes, L.P.; Merín, M.G.; Fontana, A.R.; Bottini, R.A.; Ramirez, M.L.; Morata de Ambrosini, V.I. Isolation, identification and selection of antagonistic yeast against Alternaria alternata infection and tenuazonic acid production in wine grapes from Argentina. Int. J. Food Microbiol. 2018, 266, 14–20. [Google Scholar] [CrossRef]
- Qin, X.; Xiao, H.; Cheng, X.; Zhou, H.; Si, L. Hanseniaspora uvarum prolongs shelf life of strawberry via volatile production. Food Microbiol. 2017, 63, 205–212. [Google Scholar] [CrossRef]
- Spadaro, D.; Droby, S. Development of biocontrol products for postharvest diseases of fruit: The importance of elucidating the mechanisms of action of yeast antagonists. Trends Food Sci. Technol. 2016, 47, 39–49. [Google Scholar] [CrossRef]
- Köhl, J.; Kolnaar, R.; Ravensberg, W.J. Mode of action of microbial biological control agents against plant diseases: Relevance beyond efficacy. Front. Plant Sci. 2019, 10, 845. [Google Scholar] [CrossRef]
- Delgado, N.; Olivera, M.; Cádiz, F.; Montenegro, I.; Madrid, A.; Bravo, G.; Fuentealba, C.; Pedreschi, R.; Salgado, E.; Besoain, X. Volatile Organic Compounds (VOCs) produced by Gluconobacter cerinus and Hanseniaspora osmophila displaying control effect against table grape-rot pathogens. In Proceedings of the XXVII Congreso SOCHIFIT, Arica, Chile, 5–7 November 2019. [Google Scholar]
- Liu, H.M.; Guo, J.H.; Cheng, Y.J.; Liu, P.; Long, C.A.; Deng, B.X. Inhibitory activity of tea polyphenol and Hanseniaspora uvarum against Botrytis cinerea infections. Lett. Appl. Microbiol. 2010, 51, 258–263. [Google Scholar] [CrossRef]
- Liu, H.M.; Guo, J.H.; Cheng, Y.J.; Luo, L.; Liu, P.; Wang, B.Q.; Deng, B.X.; Long, C.A. Control of gray mold of grape by Hanseniaspora uvarum and its effects on postharvest quality parameters. Ann. Microbiol. 2010, 60, 31–35. [Google Scholar] [CrossRef]
- Liu, H.M.; Guo, J.H.; Luo, L.; Liu, P.; Wang, B.Q.; Cheng, Y.J.; Deng, B.X.; Long, C.A. Improvement of Hanseniaspora uvarum biocontrol activity against gray mold by the addition of ammonium molybdate and the possible mechanisms involved. Crop Prot. 2010, 29, 277–282. [Google Scholar] [CrossRef]
- Nadai, C.; Fernandes Lemos, W.J.; Favaron, F.; Giacomini, A.; Corich, V. Biocontrol activity of Starmerella bacillaris yeast against blue mold disease on apple fruit and its effect on cider fermentation. PLoS ONE 2018, 13, e204350. [Google Scholar] [CrossRef]
- Parafati, L.; Vitale, A.; Restuccia, C.; Cirvilleri, G. Biocontrol ability and action mechanism of food-isolated yeast strains against Botrytis cinerea causing post-harvest bunch rot of table grape. Food Microbiol. 2015, 47, 85–92. [Google Scholar] [CrossRef]
- Yuan, J.; Raza, W.; Shen, Q.; Huang, Q. Antifungal activity of Bacillus amyloliquefaciens NJN-6 volatile compounds against Fusarium oxysporum f. sp. cubense. Appl. Environ. Microbiol. 2012, 78, 5942–5944. [Google Scholar] [CrossRef]
- Boussaada, O.; Saidana, D.; Chriaa, J.; Chraif, I.; Mahjoub, M.A.; Mighri, Z.; Daami, M.; Helal, A.N. Chemical composition and antimicrobial activity of volatile components of Scorzonera undulata. J. Essent. Oil Res. 2008, 20, 358–362. [Google Scholar] [CrossRef]
- Kordali, S.; Cakir, A.; Akcin, T.A.; Mete, E.; Akcin, A.; Aydin, T.; Kilic, H. Antifungal and herbicidal properties of essential oils and n-hexane extracts of Achillea gypsicola Hub-Mor. and Achillea biebersteinii Afan. (Asteraceae). Ind. Crops Prod. 2009, 29, 562–570. [Google Scholar] [CrossRef]
- Bordoloi, M.; Saikia, S.; Bordoloi, P.K.; Kolita, B.; Dutta, P.P.; Bhuyan, P.D.; Dutta, S.C.; Rao, P.G. Isolation, characterization and antifungal activity of very long chain alkane derivatives from Cinnamomum obtusifolium, Elaeocarpus lanceifolius and Baccaurea sapida. J. Mol. Struct. 2017, 1142, 200–210. [Google Scholar] [CrossRef]
- Garbeva, P.; Hordijk, C.; Gerards, S.; de Boer, W. Volatiles produced by the mycophagous soil bacterium Collimonas. FEMS Microbiol. Ecol. 2014, 87, 639–649. [Google Scholar] [CrossRef] [PubMed]
- Qadri, M.; Deshidi, R.; Shah, B.A.; Bindu, K.; Vishwakarma, R.A.; Riyaz-Ul-Hassan, S. An endophyte of Picrorhiza kurroa Royle ex. Benth, producing menthol, phenylethyl alcohol and 3-hydroxypropionic acid, and other volatile organic compounds. World J. Microbiol. Biotechnol. 2015, 31, 1647–1654. [Google Scholar] [CrossRef] [PubMed]
- Zhang, J.W.; Li, S.K.; Wu, W.J. The main chemical composition and in vitro antifungal activity of the essential oils of Ocimum basilicum Linn. var. pilosum (Willd.) Benth. Molecules 2009, 14, 273–278. [Google Scholar] [CrossRef]
- Mannaa, M.; Kim, K.D. Biocontrol activity of volatile-producing Bacillus megaterium and Pseudomonas protegens against Aspergillus and Penicillium spp. predominant in stored rice grains: Study II. Mycobiology 2018, 46, 52–63. [Google Scholar] [CrossRef] [PubMed]
- Mantzouridou, F.; Naziri, E.; Tsimidou, M.Z. Squalene versus ergosterol formation using Saccharomyces cerevisiae: Combined effect of oxygen supply, inoculum size, and fermentation time on yield and selectivity of the bioprocess. J. Agric. Food Chem. 2009, 57, 6189–6198. [Google Scholar] [CrossRef] [PubMed]
- Huang, R.; Li, G.Q.; Zhang, J.; Yang, L.; Che, H.J.; Jiang, D.H.; Huang, H.C. Control of postharvest Botrytis fruit rot of strawberry by volatile organic compounds of Candida intermedia. Phytopathology 2011, 101, 859–869. [Google Scholar] [CrossRef]
- Zhang, S.; Xu, B.; Zhang, J.; Gan, Y. Identification of the antifungal activity of Trichoderma longibrachiatum T6 and assessment of bioactive substances in controlling phytopathgens. Pestic. Biochem. Physiol. 2018, 147, 59–66. [Google Scholar] [CrossRef]
- Qi, D.; Zou, L.; Zhou, D.; Chen, Y.; Gao, Z.; Feng, R.; Zhang, M.; Li, K.; Xie, J.; Wang, W. Taxonomy and broad-spectrum antifungal activity of Streptomyces sp. SCA3-4 isolated from rhizosphere soil of Opuntia stricta. Front. Microbiol. 2019, 10, 1390. [Google Scholar] [CrossRef] [PubMed]
- Leyva, M.O.; Vicedo, B.; Finiti, I.; Flors, V.; Del Amo, G.; Real, M.D.; García-Agustín, P.; González-Bosch, C. Preventive and post-infection control of Botrytis cinerea in tomato plants by hexanoic acid. Plant Pathol. 2008, 57, 1038–1046. [Google Scholar] [CrossRef]
- Varsha, K.K.; Devendra, L.; Shilpa, G.; Priya, S.; Pandey, A.; Nampoothiri, K.M. 2,4-Di-tert-butyl phenol as the antifungal, antioxidant bioactive purified from a newly isolated Lactococcus sp. Int. J. Food Microbiol. 2015, 211, 44–50. [Google Scholar] [CrossRef] [PubMed]
- Dharni, S.; Gupta, S.; Maurya, A.; Samad, A.; Srivastava, S.K.; Sharma, A.; Patra, D.D. Purification, Characterization and In vitro Activity of 2,4-di-tert-butylphenol from Pseudomonas monteilii PsF84: Conformational and Molecular Docking Studies. J. Agric. Food Chem. 2014, 62, 6138–6146. [Google Scholar] [CrossRef]
- Raza, W.; Ling, N.; Yang, L.; Huang, Q.; Shen, Q. Response of tomato wilt pathogen Ralstonia solanacearum to the volatile organic compounds produced by a biocontrol strain Bacillus amyloliquefaciens SQR-9. Sci. Rep. 2016, 6, 24856. [Google Scholar] [CrossRef] [PubMed]
- Dhingra, O.D.; Sinclair, J.B. Basic Plant Pathology Methods, 2nd ed.; CRC Press: Boca Raton, FL, USA, 1995; ISBN 0-87371-638-8. [Google Scholar]
- Garrity, G.M. Bergey’s Manual of Systematic Bacteriology; Springer: New York, NY, USA, 2005; Volume 2, pp. 883–904. [Google Scholar]
- Choma, I.M.; Grzelak, E.M. Bioautography detection in thin-layer chromatography. J. Chromatogr. A 2011, 1218, 2684–2691. [Google Scholar] [CrossRef]

| N° Peak | RT (Min) | Main Components | RI † | RIref ‡ | %Area | Match | Activity § | Reference |
|---|---|---|---|---|---|---|---|---|
| 1 | 4.03 | 2-Butanone, 3-methyl- | 590 | 650 | 5.11 | 90 | anf | [36] |
| 2 | 4.13 | 3-Pentanone | 654 | 672 | 4.01 | 91 | anf | [37] |
| 3 | 4.30 | Propanoic acid, ethyl ester | 686 | 693 | 2.08 | 81 | anf | [41] |
| 4 | 6.60 | 2-Pentanone, 4-hydroxy-4-methyl- | 845 | 811 | 6.91 | 89 | anb/anf | [38] |
| 5 | 10.37 | Hexanoic acid | 974 | 950 | 0.69 | 92 | anf | [44] |
| 6 | 12.66 | Undecane | 1115 | 1100 | 2.04 | 93 | NR | |
| 7 | 14.89 | Dodecane, 4,6-dimethyl- | 1285 | 1325 | 0.87 | 87 | NR | |
| 8 | 15.78 | 1-Octanol, 2-butyl- | 1393 | 1277 | 1.88 | 90 | anf | [39] |
| 9 | 15.91 | 11-Methyldodecanol | 1492 | 1435 | 2.76 | 89 | NR | |
| 10 | 16.03 | 2-Isopropyl-5-methyl-1-heptanol | 1165 | 1165 | 2.50 | 88 | anf | [39] |
| 11 | 17.15 | Tetradecane | 1413 | 1400 | 2.57 | 98 | anb/anf | [32,33] |
| 12 | 17.90 | Hexadecane, 2,6,11,15-tetramethyl- | 1753 | 1792 | 4.24 | 84 | NR | |
| 13 | 18.25 | Tetradecane, 4-methyl- | 1448 | 1454 | 0.56 | 84 | NR | |
| 14 | 18.45 | Pentadecane | 1512 | 1500 | 1.59 | 97 | anb/anf | [32] |
| 15 | 18.60 | 2,4-Di-tert-butylphenol | 1555 | 1519 | 0.95 | 92 | anf | [45] |
| 16 | 19.02 | 1-Dodecanol, 2-hexyl- | 1989 | 1504 | 1.04 | 81 | NR | |
| 17 | 19.68 | Hexadecane | 1612 | 1600 | 1.67 | 97 | NR | |
| 18 | 20.84 | Octadecane | 1810 | 1800 | 1.39 | 94 | NR | |
| 19 | 21.49 | 1-Heptanol, 2,4-diethyl- | 1229 | 1229 | 2.33 | 87 | NR | |
| 20 | 22.93 | Eicosane | 2009 | 2000 | 0.59 | 82 | anb/anf | [34] |
| 21 | 23.01 | 2-Methylhexacosane | 2656 | 2656 | 0.95 | 83 | NR | |
| 22 | 23.13 | 1H-Indole-3-ethanol, acetate (ester) | 1729 | 1926 | 1.70 | 88 | NR | |
| 23 | 23.18 | 7,9-Di-tert-butyl-1-oxaspiro(4,5)deca-6,9-diene-2,8-dione | 2081 | 1929 | 1.23 | 85 | NR | |
| 24 | 23.99 | Heneicosane | 2109 | 2100 | 0.51 | 89 | anb/anf | [33,34] |
| 25 | 26.72 | Carbonic acid, octadecyl prop-1-en-2-yl ester | 2189 | 2189 | 0.50 | 85 | NR | |
| 26 | 27.57 | Ethanol, 2-butoxy-, phosphate (3:1) | 2363 | 2363 | 2.80 | 94 | NR | |
| 27 | 28.85 | Phenol, 2,4-bis(1-methyl-1-phenylethyl)- | 2702 | 2527 | 0.50 | 86 | NR | |
| 28 | 32.35 | 13-Docosenamide, (Z)- | 2625 | 2625 | 2.38 | 93 | anf | [42,43] |
| 29 | 32.89 | Squalene | 2914 | 2847 | 10.28 | 97 | NR |
Publisher’s Note: MDPI stays neutral with regard to jurisdictional claims in published maps and institutional affiliations. |
© 2021 by the authors. Licensee MDPI, Basel, Switzerland. This article is an open access article distributed under the terms and conditions of the Creative Commons Attribution (CC BY) license (https://creativecommons.org/licenses/by/4.0/).
Share and Cite
Olivera, M.; Delgado, N.; Cádiz, F.; Riquelme, N.; Montenegro, I.; Seeger, M.; Bravo, G.; Barros-Parada, W.; Pedreschi, R.; Besoain, X. Diffusible Compounds Produced by Hanseniaspora osmophila and Gluconobacter cerinus Help to Control the Causal Agents of Gray Rot and Summer Bunch Rot of Table Grapes. Antibiotics 2021, 10, 664. https://doi.org/10.3390/antibiotics10060664
Olivera M, Delgado N, Cádiz F, Riquelme N, Montenegro I, Seeger M, Bravo G, Barros-Parada W, Pedreschi R, Besoain X. Diffusible Compounds Produced by Hanseniaspora osmophila and Gluconobacter cerinus Help to Control the Causal Agents of Gray Rot and Summer Bunch Rot of Table Grapes. Antibiotics. 2021; 10(6):664. https://doi.org/10.3390/antibiotics10060664
Chicago/Turabian StyleOlivera, Matías, Ninoska Delgado, Fabiola Cádiz, Natalia Riquelme, Iván Montenegro, Michael Seeger, Guillermo Bravo, Wilson Barros-Parada, Romina Pedreschi, and Ximena Besoain. 2021. "Diffusible Compounds Produced by Hanseniaspora osmophila and Gluconobacter cerinus Help to Control the Causal Agents of Gray Rot and Summer Bunch Rot of Table Grapes" Antibiotics 10, no. 6: 664. https://doi.org/10.3390/antibiotics10060664
APA StyleOlivera, M., Delgado, N., Cádiz, F., Riquelme, N., Montenegro, I., Seeger, M., Bravo, G., Barros-Parada, W., Pedreschi, R., & Besoain, X. (2021). Diffusible Compounds Produced by Hanseniaspora osmophila and Gluconobacter cerinus Help to Control the Causal Agents of Gray Rot and Summer Bunch Rot of Table Grapes. Antibiotics, 10(6), 664. https://doi.org/10.3390/antibiotics10060664

